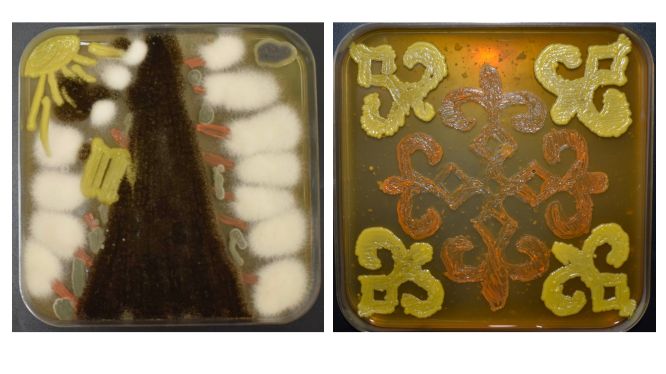

Кейде ғылым қатаң формула мен зертхана шеңберінен шығып, өнерге де айнала алады. Aqshamnews.kz тілшісі микроағзалар арқылы сурет салатын ерекше өнер иесі, микробиолог Айзада Жақсылықпен сұхбаттасып, көзге көрінбейтін әлем қалай бояуға айналатынын білді.
Неліктен микробиология?
Айзада Жақсылық Қызылорда қаласында дүниеге келген. Биотехнология мамандығы бойынша бакалавриат пен магистратураны ҚазҰАЗУ-да тәмамдап, бүгінде микробиология бағыты бойынша ҚазҰУ-да докторантурада білім алып жүр.

Оның айтуынша, микробиологияға келуіне көзге көрінбейтін, бірақ бүкіл экожүйеге әсер ететін микроағзалар әлеміне деген қызығушылық себеп болған.
"Микроағзалар тағам өндірісінде, медицинада, биотехнологияда кең қолданылады. Ал олардың көзге көрінбесе де, табиғат пен адам өміріндегі рөлі орасан. Бұл – зерттеуге әбден лайық әлем, - дейді ол.
"Ғылымда нәтиже бірден шықпайды": зертханадағы көрінбейтін еңбек қандай?
Қазір Айзада Микробиология және вирусология ғылыми-өндірістік орталығында, тағамдық микробиология зертханасында ғылыми қызметкер болып жұмыс істейді. Мұнда үш жылға созылатын ауқымды ғылыми жобалар жүзеге асырылады. Жоба аясында ауыл шаруашылығына арналған биопрепараттар мен тағамдық ашытқылар өндіріліп, нарыққа шығарылады.
"Менің бір күнім зертханада жоспарлау мен дайындықтан басталады. Стерильділік сақтау, есептеу жүргізу, үлгілерді дұрыс орналастыру және нәтижені бірнеше рет тексеру күнделікті жұмысымның ажырамас бөлігі. Ғылымда нәтиже бірден шықпайды. Сондықтан шыдамдылық пен дәлдік – басты қағида", - дейді Айзада.
"Микроағзалармен сурет салу үшін бәрін алдын ала есептеп, жоспарлау қажет"
Айзада үшін микробиология тек зерттеу емес, сонымен қатар өнер. Ол микроағзалармен сурет салу (agar art) – үлкен білім мен шығармашылықты талап ететін ерекше бағыт екенін айтады. Себебі әр бактерия мен саңырауқұлақтың өзіне тән өсу ортасы, температурасы, түсі бар. Ал сурет салу үшін осының бәрін алдын ала есептеп, жоспарлау қажет.
"Микроағзалар тірі. Олар әрдайым сен сызған сызықпен өседі деген кепіл жоқ. Кейде бір күн өсіріп, жетіспейтін тұстарын толықтырып, қайтадан термостатқа қоямыз. Эскизден гөрі импровизация басым болады", - дейді микробиолог.
Оның айтуынша, бір Петри табақшасында бірнеше микроағзаны қолдану да оңай емес. Әр ағзаның талаптары әртүрлі болғандықтан, әдемі әрі түрлі-түсті сурет алу үшін көп еңбектенуге тура келеді.
Халықаралық байқаудағы тәжірибе мен келешекке жоспар
Айзада Жақсылық жақында Өзбекстанда өткен халықаралық Agar Art байқауына қатысып, Қазақстан атынан өнер көрсеткен. Байқау шарты бойынша ешқандай бояу мен фильтр қолдануға болмайды: қағаз орнына – қоректік орта, бояу орнына – микроағзалар пайдаланылған.

Қазақстанды танытатын жұмыс жасауды мақсат еткен зерттеуші ту бейнесін, текеметтегі қошқар мүйіз оюын микроағзалар арқылы салған. Сонымен қатар шахмат тақтасы, сакураның гүлдеуі және саябақтағы серуен тақырыбындағы жұмыстарын ұсынған.
"Байқауда жүлделі орындар өзбекстандық қатысушыларға бұйырды. Бірақ өкініш жоқ. Бұл мен үшін үлкен тәжірибе болды", - дейді ол.

Айзада алдағы уақытта өз саласында ірі жобаларға қатысып, Қазақстан ғылымының дамуына үлес қосып, зерттеу нәтижелерін нақты өнімге айналдыруды көздейтінін айтты.